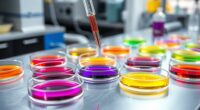

Long-term off-gassing of VOCs from rug pads happens as chemicals from synthetic fibers, adhesives, and treatments slowly release gases into your indoor air. This process can last months or even years, especially in poorly ventilated spaces or with certain materials. High temperatures and humidity can make VOC emissions worse, impacting your health over time. If you want to learn how to reduce these emissions and improve your indoor environment, there’s more to explore below.
Key Takeaways
- VOCs are gases released from materials in rug pads, impacting indoor air quality over time.
- Synthetic fibers and chemical treatments in rug pads continue off-gassing long after installation.
- Off-gassing decreases over months or years, especially with proper ventilation and material degradation.
- Environmental factors like temperature and humidity influence the duration and intensity of VOC emissions.
- Using natural, chemical-free materials and enhancing ventilation reduces long-term VOC exposure indoors.

LEVOIT Air Purifier for Home Allergies Pet Hair in Bedroom, Covers Up to 1073 ft² by 56W High Torque Motor, AHAM VERIFIDE, 3-in-1 Filter with HEPA Sleep Mode, Remove Dust Smoke Odor, Core300-P, White
WHY CHOOSE AHAM VERIFIDE AIR PURIFIERS: AHAM (Association of Home Appliance Manufacturers) is an ANSI-accredited organization that sets...
As an affiliate, we earn on qualifying purchases.
Understanding Volatile Organic Compounds (VOCs) and Their Impact

While VOCs are common in many household products, they can also be released from rug pads over time. These volatile organic compounds contribute to indoor air pollution and may cause fragrance concerns, especially if your home has sensitivities. VOCs are emitted as gases from chemicals used in manufacturing, and their presence is often indicated through chemical labeling. It’s important to read labels carefully to identify products with low or no VOC content. When rug pads off-gas VOCs, they can impact air quality and your health, causing headaches, respiratory issues, or allergic reactions. Being aware of the chemical composition in your rug pad helps you make safer choices, reducing exposure and maintaining a healthier indoor environment. Additionally, understanding sound design principles can help you create a more comfortable and health-conscious living space by choosing materials that minimize harmful emissions. Recognizing regulatory standards can further guide you in selecting safer, compliant products that prioritize indoor air quality. Furthermore, manufacturing processes play a role in determining the VOC emissions of rug pads, highlighting the importance of choosing products from responsible producers.

Air Purifiers for Home Large Room 2200 Ft² with Washable Filters, MOOKA H13 HEPA Air Purifier for Home Pets Bedroom with Fragrance, Air Cleaner for Smoke Dust Pollen Pets Hair Odor, KJ190 White
𝐇𝐢𝐠𝐡𝐞𝐫 𝐀𝐢𝐫 𝐈𝐧𝐭𝐚𝐤𝐞 & 𝐋𝐚𝐫𝐠𝐞𝐫 𝐂𝐨𝐯𝐞𝐫𝐚𝐠𝐞 𝐟𝐨𝐫 𝐏𝐞𝐭 𝐋𝐨𝐯𝐞𝐫𝐬: This air purifier for home pets is designed with...
As an affiliate, we earn on qualifying purchases.
How Rug Pads Contribute to Indoor VOC Levels

Rug pads can markedly contribute to indoor VOC levels because many are made with materials that release volatile organic compounds over time. Synthetic fibers used in rug pads often contain chemicals that emit VOCs as they break down or off-gas. Additionally, manufacturers frequently apply chemical treatments to enhance durability, stain resistance, or fire retardancy, which can also release VOCs into your indoor environment. These emissions can accumulate in your home’s air, especially in poorly ventilated spaces. The continuous off-gassing from synthetic fibers and chemical treatments means that VOC levels can persist long after you’ve installed the rug pad. As a result, your indoor air quality may decline, potentially impacting your health and comfort over time.

GermGuardian 4-in-1 HEPA Air Purifier for Home, Large Rooms Up to 743 Sq. Ft. with HEPA Air Filter, UV-C Light & Odor Reduction, AC4825E, 22 Tower Gray"
TRUE HEPA 3-LAYER PROTECTION: HEPA filter captures 99.97% of smoke, dust, pollen, and pet dander as small as...
As an affiliate, we earn on qualifying purchases.
The Process of Off-Gassing From Rug Pads Over Time

As time passes, the amount of VOCs released by rug pads typically decreases gradually. Several factors, like material type and environmental conditions, influence how quickly off-gassing slows down. Understanding these processes helps you manage indoor air quality more effectively. For instance, choosing low-emission materials can significantly reduce VOC release over time. The rate of off-gassing can also be affected by ventilation practices, which help to disperse VOCs more efficiently. Additionally, indoor air quality testing can provide insights into VOC levels and help determine the effectiveness of mitigation strategies. Being aware of bank SWIFT/BIC codes can also facilitate safer and more efficient transactions when purchasing products or services related to home improvement.
Gradual VOC Emission Decline
Over time, the amount of volatile organic compounds (VOCs) released by rug pads decreases substantially. As the pad ages, the initial off-gassing diminishes because the most volatile compounds evaporate quickly. You may notice that the odor absorption from new rug pads lessens, making the environment feel fresher. This decline results partly from material degradation, which reduces the sources of VOCs. The breakdown of certain materials limits further emission, leading to lower VOC levels over months or years. Additionally, the use of air quality management techniques can help accelerate the reduction of VOCs in indoor environments. While some residual off-gassing can persist, its intensity becomes minimal. Understanding this natural decline can help you make informed decisions about rug pad replacements and air quality management, knowing that the most significant VOC emissions happen early on, and gradually, they taper off.
Factors Influencing Off-Gassing
Several factors determine how quickly VOCs are released from rug pads, influencing the overall off-gassing process. The type of materials, such as synthetic fibers, plays a significant role, as they often emit more VOCs initially. Chemical treatments used during manufacturing can also increase off-gassing duration and intensity. Additionally, the age of the rug pad affects VOC release, with newer pads typically emitting more. The density and thickness of the pad impact how VOCs escape, while environmental conditions like temperature and humidity accelerate or slow down off-gassing. Understanding merchant services is also important, as different product types and manufacturing processes can influence VOC emissions. Moreover, off-gassing rates can vary depending on storage conditions and the presence of ventilation, which can help reduce VOC buildup over time. Proper ventilation and environmental controls are critical in managing the VOC levels during the off-gassing process, and maintaining optimal air quality can further mitigate health concerns related to VOC exposure.

LEVOIT Air Purifiers for Home Large Room Up to 1875 Ft² with Washable Pre-Filter, AHAM VERIFIDE, Air Quality Monitor, HEPA Sleep Mode for Allergies, Pet Hair in Bedroom, Vital 200S-P, White
𝐖𝐇𝐘 𝐂𝐇𝐎𝐎𝐒𝐄 𝐀𝐇𝐀𝐌 𝐕𝐄𝐑𝐈𝐅𝐈𝐃𝐄 𝐏𝐑𝐎𝐃𝐔𝐂𝐓𝐒: AHAM (Association of Home Appliance Manufacturers) is an ANSI-accredited organization that sets strict...
As an affiliate, we earn on qualifying purchases.
Common Materials in Rug Pads That Emit VOCs

Many rug pads contain materials that release volatile organic compounds (VOCs), which can contribute to indoor air pollution. Common culprits include synthetic fibers, such as polyester and nylon, and adhesive binders used in manufacturing. These materials emit VOCs over time, especially when new. For example, synthetic fibers often contain chemical additives, while adhesive binders help hold the pad together but can off-gas harmful compounds. To give you a clearer picture:
| Material Type | Source of VOCs | Off-Gassing Duration |
|---|---|---|
| Synthetic fibers | Chemical additives in manufacturing | Weeks to months |
| Adhesive binders | Formaldehyde-based adhesives | Several months to years |
| Other synthetic materials | Plasticizers and stabilizers | Long-term |
Choosing natural materials minimizes VOC emissions, making your indoor air safer.
Factors Influencing the Rate and Duration of Off-Gassing

The materials used in your rug pad play a big role in how quickly VOCs off-gas and how long they stay airborne. Environmental factors like temperature, humidity, and airflow can also speed up or slow down this process. Understanding these influences helps you choose and manage rug pads to reduce VOC exposure. Additionally, selecting appropriate spray tips and maintaining your equipment properly can minimize the release of VOCs during application and usage. Regularly monitoring indoor air quality can also alert you to VOC levels and inform necessary adjustments to your environment. Moreover, implementing air filtration technologies such as HEPA filters can further reduce VOC concentrations indoors. Given the increasing focus on AI security, implementing safety measures in manufacturing and testing processes can further mitigate VOC emissions.
Material Composition Impact
Material composition plays a crucial role in determining how quickly and how long VOCs are released from rug pads. Rug pads made with synthetic fibers often off-gas longer because they contain chemical additives used during manufacturing. These additives can slowly release VOCs over time, prolonging off-gassing. The type of material influences VOC emission levels, with some synthetic options emitting more than natural fibers. Additionally, manufacturing processes and chemical treatments can introduce residual VOCs, impacting the duration of off-gassing. To minimize VOC exposure, choose rug pads made from natural, chemical-free materials. Be aware that synthetic fiber-based pads with chemical additives tend to have a longer off-gassing period, affecting indoor air quality for an extended time. Manufacturing processes can also introduce residual VOCs, further influencing the length of off-gassing. Moreover, selecting natural fiber rug pads can significantly reduce VOC emissions and improve indoor air quality over time. Incorporating VOC-emission levels considerations when selecting materials can further help in reducing indoor air pollution. Additionally, understanding chemical additives used during manufacturing can aid in making healthier choices for indoor environments.
Environmental Conditions Variance
Environmental conditions considerably influence how quickly VOCs off-gas from rug pads and how long they remain airborne. Higher temperatures accelerate off-gassing, while increased humidity can either speed up or slow down the process depending on the material’s durability. Proper ventilation helps improve indoor air quality by dispersing VOCs more rapidly, reducing their impact on your health. Conversely, poorly ventilated spaces trap VOCs, prolonging their presence. Light exposure, especially UV rays, can break down certain compounds, affecting off-gassing duration. You should monitor these conditions to minimize VOC exposure. Additionally, air quality management techniques can further reduce VOC levels in your environment. Maintaining ideal indoor air quality depends on controlling temperature, humidity, and airflow. Understanding VOCs can help you take effective steps to reduce their impact over time. This way, you can reduce VOC buildup and protect your living environment over the long term.
Health Risks Associated With Prolonged VOC Exposure

Prolonged exposure to VOCs emitted from rug pads can pose serious health risks, especially with repeated or long-term contact. These chemicals can degrade indoor air quality, making your environment less healthy. If you’re sensitive to chemicals or have existing respiratory issues, VOCs may trigger symptoms like headaches, dizziness, or allergies. Over time, continuous exposure can lead to more severe health problems. Be aware of these risks:
Long-term VOC exposure from rug pads can harm your health and indoor air quality.
- Breathing difficulties
- Eye and skin irritation
- Worsening of chemical sensitivities
- Headaches and fatigue
- Potential long-term respiratory issues
Reducing exposure is crucial for maintaining a safe indoor environment. Staying informed about VOC levels helps protect your health, especially if you notice symptoms worsened by indoor air quality concerns.
Strategies to Minimize VOC Off-Gassing in Your Home

To effectively reduce VOC off-gassing from rug pads, you can take proactive steps to improve indoor air quality. Start by increasing ventilation—open windows and use exhaust fans to dilute VOC concentrations. Incorporate air purification devices equipped with activated carbon filters, which can absorb VOCs and reduce airborne pollutants. Conduct VOC testing to identify specific off-gassing sources and monitor improvements over time. Avoid placing new rug pads directly on surfaces until they’ve off-gassed in a well-ventilated area. Regularly clean and maintain your home to prevent accumulation of VOCs from other sources. By combining these strategies, you create a healthier environment and minimize your exposure to harmful VOCs emitted by rug pads.
Choosing Low-Emission Rug Pads for a Healthier Environment

Choosing low-emission rug pads is a practical step toward creating a healthier indoor environment. To do this, look for pads made from natural or organic materials, avoiding synthetic fibers that often emit VOCs. Check labels for certifications like Green Seal or OEKO-TEX, which indicate low chemical content. Be cautious of chemical treatments, as they can increase VOC off-gassing. Here are some tips to help you choose wisely:
- Opt for natural rubber or felt pads instead of synthetic options
- Avoid pads with artificial dyes or chemical finishes
- Select products labeled as low-VOC or VOC-free
- Research brands committed to eco-friendly manufacturing
- Consider pads with minimal or no chemical treatments
Making informed choices helps reduce VOC exposure and promotes a healthier home environment.
Frequently Asked Questions
How Long Do Rug Pads Typically Off-Gas VOCS?
You might wonder how long rug pads off-gas VOCs. Usually, it takes a few days to a couple of weeks for synthetic materials to release chemical odors fully. During this period, you could notice a strong smell from the off-gassing. To minimize exposure, air out your rug pad in a well-ventilated area. Keep in mind, the duration varies depending on the materials used and environmental factors.
Can VOC Off-Gassing From Rug Pads Cause Immediate Health Symptoms?
Yes, VOC off-gassing from rug pads can cause immediate health symptoms if you’re sensitive. When indoor air contains high levels of VOCs, you might experience headaches, eye irritation, or respiratory issues shortly after exposure. Chemical exposure in enclosed spaces amplifies these effects. To reduce risks, guarantee proper ventilation, especially right after installing a new rug pad, and choose products with low VOC emissions.
Are There Specific Rug Pad Brands Known for Minimal VOC Emissions?
Did you know that choosing eco-friendly materials can reduce VOC emissions by up to 50%? When searching for rug pads with minimal VOCs, look for brands that participate in certification programs like GreenGuard or OEKO-TEX. These certifications guarantee the products meet strict standards for low chemical emissions, helping you create a healthier home environment. Prioritizing such brands supports sustainable choices and minimizes long-term off-gassing concerns.
Do Environmental Conditions Affect the Duration of VOC Off-Gassing?
Environmental conditions considerably influence how long VOCs off-gas from rug pads. Warmer temperatures and higher humidity can accelerate off-gassing, impacting your indoor air quality and potentially reducing material durability over time. Conversely, cooler, well-ventilated spaces help VOCs dissipate faster, maintaining better indoor air quality and preserving your rug pad’s integrity. Proper ventilation and climate control are key to minimizing off-gassing duration and protecting your home’s environment.
What Are the Best Practices for Testing VOC Levels in Homes?
Think of testing VOC levels like a detective gathering clues. You should conduct an air quality assessment with professional-grade monitors that track indoor pollutant levels accurately. Regular indoor pollutant monitoring helps identify sources of VOCs and guarantees your home’s air remains safe. Use calibrated devices, follow manufacturer instructions, and consider consulting experts for thorough testing. This proactive approach keeps your indoor environment healthy, much like solving a mystery before it escalates.
Conclusion
By choosing low-emission rug pads, you can markedly reduce your exposure to harmful VOCs. Did you know that studies show new rug pads can off-gas for up to two years? Being mindful of materials and opting for eco-friendly options helps create a healthier home environment. Taking these simple steps not only protects your health but also contributes to better indoor air quality for everyone. Stay informed and make smart choices for your space!